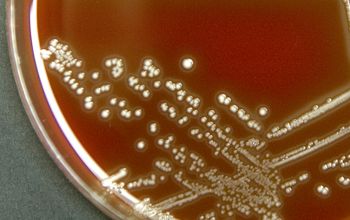

Aerococcus viridans
-
General information
Taxonomy
Family: Aerococcaceae
Natural habitats
They are in the air and dust and on the skin of people, and have been described as an airborn organism prevalent in occupied rooms.
Aerococci could be confused with streptococci and staphylococci since they have many characteristics in common, and this may account for the fact that the presence of A. viridans has not often been reported in the hospital environment or in clinical specimens.
Clinical significance
A. viridans has been noted as a contaminant in clinical cultures and infrequently as a clinical significant isolate from cases of endocarditis and bacteremia.
-
Gram stain
Gram positive cocci,
grouped in pairs, tetrads, clusters or irregular groups.
-
Culture characteristics
-
Microaerofiel Facultatief anaeroob)
BA: colonies are α-hemolytic, that may be confused with those of either viridans group streptococci or enterococci.
Greening reaction is produced on blood agar presumably as a result of H2O2 production.
McConkey: no growth
BBAØ: no growth
They grow poorly, if at all, under anaerobic conditions.
-
-
Characteristics
-
References
James Versalovic et al.(2011) Manual of Clinical Microbiology 10th Edition
Karen C. Carrol et al (2019) Manual of Clinical Microbiology, 12th Edition